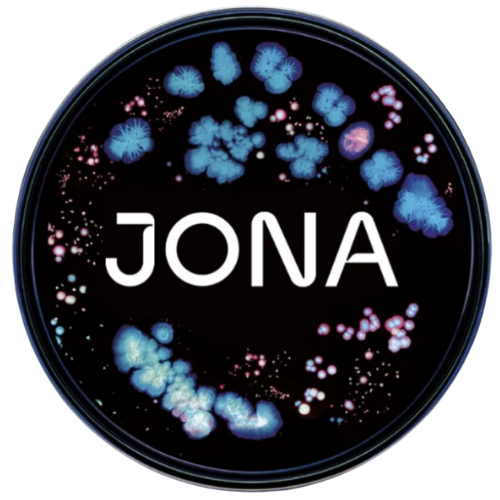

Votre microbiote intestinal sous la loupe
JONA, c’est bien plus qu’un simple test de selles.
Cette technologie de pointe utilise le séquençage métagénomique et l’intelligence artificielle pour analyser en profondeur la composition de votre microbiote intestinal.
Vous recevez un portrait clair, fiable et personnalisé, basé sur les données scientifiques les plus récentes — pour enfin comprendre ce qui se passe à l’intérieur de vous.
Que vous cherchiez Ă :
-
retrouver un meilleur confort digestif,
-
améliorer votre énergie,
-
ou soutenir votre bien-ĂŞtre global,
JONA vous offre des réponses concrètes… et un plan d’action clair pour avancer.
Â

Décortiquez votre microbiote intestinal
et accédez à une santé optimale grâce à des résultats 100 % personnalisés, propulsés par l’intelligence artificielle.
Le microbiote: au cœur de votre santé
Â
Saviez-vous que votre microbiote intestinal abrite plus de 38 milliards de micro-organismes: bactéries, levures, virus et autres acteurs invisibles qui influencent profondément votre santé?
La science actuelle démontre que cette communauté vivante est étroitement liée à une multitude de fonctions vitales, dont:
-
la digestion
-
la gestion du poids
-
les performances physiques
-
la santé mentale
-
la peau
-
et même la longévité
Un microbiote équilibré est l’un des fondements essentiels du bien-être global.
Il agit comme un chef d’orchestre silencieux qui influence vos niveaux d’énergie, votre humeur, votre système immunitaire… et bien plus encore.
Chez nous, nous croyons que de nombreuses réponses restées sans solution jusqu’à maintenant se trouvent précisément là : au cœur de votre microbiote intestinal.
Pour comprendre et trouver des réponses logées au cœur de votre microbiote intestinal
Votre microbiome joue un rôle fondamental dans plusieurs aspects de votre santé globale :
-
votre digestion,
-
votre peau,
-
votre métabolisme,
-
votre cerveau,
-
et mĂŞme vos performances physiques.
Ces milliards de micro-organismes influencent silencieusement votre bien-ĂŞtre au quotidien.
Grâce au test JONA, vous obtenez un aperçu complet et personnalisé de votre état de santé, fondé sur une analyse métagénomique avancée et les recherches scientifiques les plus à jour.
👉 Une clé puissante pour comprendre ce que votre corps essaie de vous dire… et agir avec clarté et précision.

Santé intestinale
Plongez au cœur de votre microbiote pour mieux comprendre vos inconforts digestifs… et les apaiser naturellement.

Santé de la peau
Votre peau parle… et votre microbiote en détient souvent la clé. Comprenez cette connexion pour soutenir l’éclat et l’équilibre cutané de l’intérieur.

Santé métabolique
Découvrez comment votre microbiote influence votre métabolisme et soutient votre poids, votre énergie et votre bien-être.

Santé du cerveau
Découvrez comment votre microbiote influence votre clarté mentale, votre humeur et vos fonctions cognitives.

Performances physiques
Un microbiote équilibré soutient votre énergie, votre récupération et vos résultats physiques. Mieux le connaître, mieux performer.

Bien-ĂŞtre global
Adoptez des recommandations ciblées selon votre microbiote pour soutenir votre équilibre intérieur.
Comment ça fonctionne?
Â
Voici les étapes simples et claires du processus JONA, de la commande jusqu’à l’obtention de vos résultats personnalisés.
Un parcours guidé, sans stress, vers une meilleure compréhension de votre santé intestinale.

Étape 1: commande
Passez votre commande en ligne et recevez le kit JONA chez vous, rapidement et discrètement. Sans déplacement nécessaire et prête à l’emploi.

Étape 2: échantillon
Un prélèvement simple et rapide, à faire à la maison en suivant les instructions fournies, en quelques minutes, grâce à un guide clair et facile à suivre.

Étape 3: analyse
Expédiez votre échantillon à notre laboratoire certifié. Nos experts analysent votre microbiote en profondeur à l’aide des technologies les plus avancées.

Étape 4: résultats
Recevez vos résultats,100% personnalisés, accompagnés de recommandations basées sur les données scientifiques les plus récentes.
Recevez vos résultats JONA en 2 à 3 semaines
Une fois votre échantillon envoyé, vous recevrez vos résultats détaillés en ligne dans un délai de 2 à 3 semaines.
Vous pourrez également les partager avec votre professionnel de la santé pour un suivi encore plus précis.
Résultats en français
L’interface JONA est disponible en français! Vous profiterez d’une plateforme claire, intuitive et accessible dans la langue de votre choix, pour une compréhension optimale de vos données et de vos recommandations.
Une analyse complète, unique en son genre
JONA est bien plus qu’un simple test de microbiote.
C’est une plongée approfondie au cœur de votre bien-être intestinal, soutenue par les technologies les plus avancées en intelligence artificielle (IA) et des recherches scientifiques rigoureuses.
Grâce à une analyse métagénomique de pointe, JONA vous fournit des informations personnalisées sur l’état de votre microbiome et vous propose des actions concrètes, adaptées à votre réalité.
🎯 Un outil précieux pour…
✔️ Optimiser votre digestion
✔️ Réduire l’inflammation
✔️ Améliorer votre énergie, votre humeur et votre équilibre global
Un test soutenu par des experts
Ce test a été développé et validé par une équipe multidisciplinaire composée de :
✔️ Cliniciens
✔️ Scientifiques
✔️ Diététiciens spécialisés en microbiote
Vos résultats personnalisés & recommandations ciblées
Chaque personne est unique, votre microbiote aussi.
JONA utilise l’intelligence artificielle (IA) pour analyser en profondeur les données issues de votre échantillon, puis les croise avec vos objectifs de santé et vos besoins spécifiques (digestion, énergie, peau, métabolisme, etc.).
Vous recevez des recommandations concrètes, ciblées et actionnables, directement liées à votre profil unique.
Voici un exemple de tableau de bord JONA:
Il vous permet de visualiser vos résultats de façon simple et intuitive, avec des pistes claires pour optimiser votre bien-être.
Prête à passer à l’action?
Plongez dans l’analyse de votre microbiome et découvrez les clés de votre bien-être digestif et global.
Commandez dès maintenant et amorcez votre chemin vers un meilleur équilibre de santé.
Je veux me procurer mon test JONA!